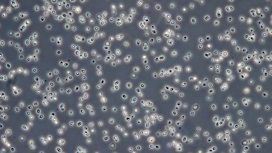

Living at the Edge: Life in Extreme Environments
Bridget Kendall presents an ideas discussion show in which some of the world's most eminent minds explore extreme living and synthetic biology in the sea, on land and in space.
Bridget Kendall and her guests explore extreme living and what it tells us, from human exploration to deep sea fish and synthetic biology. NASA scientist Lynn Rothschild is a pioneer in the field of astrobiology, interested in probing the limits of life on earth, to better understand where we might find life signs elsewhere in the universe. Oliver Crimmen is the Fish Curator at the Natural History Museum in London. He's an expert on how some sea creatures can survive both freezing and hot water - and several miles beneath the surface of our oceans. And explorer Rosie Stancer takes her own body to the edge - with solo trips to both the South Pole and the Arctic North, and a new expedition planned across China's largest desert.
(Image credit: Science Photo Library).
Last on
![]()
Indestructible organism
Nasa astrobiologist Lynn Rothschild describes a self-regenerating bacterium.
Dr. Lynn J. Rothschild
Dr Rothschild is passionate about revealing the meaning of
life in its environment on earth or elsewhere in the universe, while at the
same time pioneering the use of synthetic biology to enable space exploration.
She believes that just as travel abroad permits new insights into our home, so
too the search for life elsewhere has allowed a more mature scientific,
philosophical and ethical perception of life on Earth.
She is an evolutionary biologist and astrobiologist at
NASA's Ames Research Center.
At Ames, her research has focused on how life, particularly
microbes, has evolved in the context of the physical environment, both on Earth
and potentially beyond our planet's boundaries. She is a founding figure in the
field of astrobiology where her current research includes examining a
protein-based scenario for the origin of life, hunting for the most radiation
resistant organisms, and determining signatures for life on extrasolar planets.
Her lab is also now working on the use of synthetic biology for NASA.
Oliver Crimmen
Oliver Crimmen is the Fish Curator in the Vertebrates
Division of the Natural History Museum. He has been at the Museum since 1973,
joining when he was just 19. He is responsible for preserving one of the most
important fish collections in the world, which includes around 750,000
specimens.
Photo: The angler fish Oliver brought into the studio.
His stand out moments working at the museum with incredible
underwater creatures include “Helping with large specimen preservation projects
such as the Thames whale, the giant squid, and working with British artist Damien Hirst’s large shark
artworks”. Last year Oliver went into work and found a fish had been named
after him. P. olliei, which lives in the torrential mountain rivers of Myanmar
and clings to cliffs with its modified fins in a feat of extreme survival.
Ollie has also collaborated with a major swim suit
manufacturer on a hydrodynamic swimsuit, using sharkskin to reduce drag while
in the water. The project brought together expertise from the scientific,
artistic and commercial world.
Rosie Stancer
Since 1996, Rosie Stancer has been a polar athlete and
explorer. In 2003 she skied solo to the south pole in just short of 43 days,
beating previous speed records by a week, all whilst hauling a sledge more than
twice her weight.
In 2007, she was very close to being the first woman to
reach the North Pole on a solo mission, only to be thwarted by news that her
pilots would have risked their lives on the fast melting ice, had they picked
her up from the actual pole. She also amputated two of her own toes without
anaesthetic during the ill-fated mission.
For 2016, she has plans to trek 1,000 km through the Chinese
Taklamakan desert, the translation of which is ‘the desert you go in and don’t
come out’.
She is also a wife and mother of three and stands at 5’3” or
5’4”, depending on the report. Her small stature is often emphasized in
contrast with the archetype of a towering bearded male explorer. She is the
great-niece of the Late Queen Mother and through her husband related to Sir
Ernest Shackleton’s geologist, Jock Wordie.
She has previously been described as a ‘cross between
Tinkerbell and the Terminator’. She works with the charity Special Olympics UK.
Broadcast
- Sat 6 Aug 2016 11:00ѿý Radio 4 FM